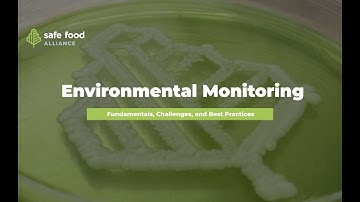
Environmental Monitoring - A Comprehensive Guide

⬇ DOWNLOAD NOW
Jika muncul iklan pop-up, tutup lalu klik tombol kembali
Download lagu Environmental Monitoring Program Sampling: A Step-by-Step Guide secara gratis hanya untuk keperluan promosi. Dukung artis favorit kamu dengan membeli musik original di iTunes atau platform resmi lainnya.
 Environmental Monitoring Program (EMP) Sample Collection
Environmental Monitoring Program (EMP) Sample Collection How to Set Up a Sampling Zone for an Environmental Monitoring Program
How to Set Up a Sampling Zone for an Environmental Monitoring Program SAMPLING | Environmental Sponge & Swab Sampling Training
SAMPLING | Environmental Sponge & Swab Sampling Training Environmental Surface Sampling Using Contact Agar Plates
Environmental Surface Sampling Using Contact Agar Plates Environmental Monitoring - A Comprehensive Guide
Environmental Monitoring - A Comprehensive Guide Environmental Monitoring (EM)
Environmental Monitoring (EM) Environmental monitoring using Air sampler
Environmental monitoring using Air sampler Biggest Environmental Monitoring Challenges to Consider
Biggest Environmental Monitoring Challenges to Consider